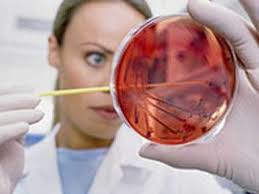
Testul Babes Papanicolau

Obstetrică - ginecologie reprezintă o specialitate medicală care se ocupă cu studiul morfo-fiziopatologiei organelor genitale feminine ca parte a întregului organism, al proceselor biologice legate de reproducere și tratamentul stărilor patologice din sfera genitala , consultatii si tratamentul afectiunilor in domeniul ginecologiei, diagnosticul si supravegherea evolutiei sarcinii, ecografie urmarire sarcina, inclusiv morfologie fetala, ecografie transvaginala, diagnosticul si tratamentul sterilitatii, implantare/extragere sterilet, examen secretie vaginala (Babes-Papanicolau), cultura col+antibiograma, chiuretaj uterin, interventii de mica chirurgie.
Testul Papanicolau (care se mai numeste si frotiul Papanicolau) face parte din examenul ginecologic de rutina. Testul Papanicolau este folosit cu scopul identificarii modificarilor celulare anormale de la nivelul cervixului si pentru screeningul cancerului de col uterin. Testul Papanicolau se face obligatoriu o data pe an , de catre femeile care si au inceput viata sexuala.
In Romania, cancerul de col uterin este prima cauza de mortalitate prin cancer la cu varsta cuprinsa intre 15 si 44 de ani (Ministerul Sanatatii)
Tara noastra este pe primul loc in Europa in clasamentul incidentei cacerului de col uterin, cat si al mortalitatii provocate de acesta (Ministerul Sanatatii)
Peste 3.000 de romance sunt nou diagnosticate in fiecare an cu cancer de col uterin (Ministerul Sanatatii)
In prezent este cea mai buna metoda de depistare a leziunilor precanceroase ale colului uterin este testarea citologica Babes-Papanicolau
Testu Babes Papanicolau se realizeaza in timpul consultului ginecologic printr-un procedeu simplu, rapid si nedureros; recoltarea se realizeaza in afara perioadei menstruale
presupune colectarea de celule epiteliale de la nivelul colului uterin si examinarea la microscop a acestora.
Cum te pregatesti? Pentru ca examenul citologic sa fie corect interpretat, este important ca pacientele sa evite timp de 48 de ore contactul sexual, utilizarea tampoanelor/spalaturilor/medicatiei intravaginale.
Cum se interpreteaza? Raportarea rezultatelor testului se poate realiza in mai multe moduri, dar in prezent, cea mai utilizata si moderna este clasificarea Bethesda.Un Pap-test anormal presupune incadrarea rezultatului in clasele III-V conform clasificarii Papanicolaou, sau, in cazul sistemului Bethesda, prezenta anomaliilor celulelor epiteliale scuamoase/glandulare.
Ce este de facut in cazul unui rezultat anormal?
Repetarea testului PAP la un anumit interval de timp (4-6 luni);
Efectuarea suplimentara a unui test HPV, pentru a vedea daca este prezent virusul HPV cu risc crescut;
In cazul in care si cel de-al doilea PAP-test iese anormal si/sau testarea HPV are un rezultat pozitiv, se efectuarea colposcopia, pentru a examina colul uterin si a determina daca sunt prezente leziuni anormale.
In cazul in care se evidentiaza o leziune la nivelul colului uterin, aceasta trebuie obligatoriu verificata histopatologic prin biopsie – aceasta fiind singura metoda care poate stabili diagnosticul cu certitudine.
Daca pacienta a avut, în trecut, un test Papanicolau anormal, este important sa semnaleze acest lucru medicului înainte de a efectua testul Papanicolau prezent.
Un Pap-test anormal nu inseamna obligatoriu cancer de col: unele infectii, menopauza, prezenta unui sterilet, etc, pot sa influenteze rezultatul testului.